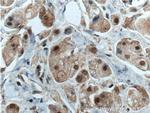
CDK7 Antibody in Immunohistochemistry (Paraffin) (IHC (P))

Search
Proteintech
CDK7 Polyclonal Antibody
{{$productOrderCtrl.translations['antibody.pdp.commerceCard.promotion.promotions']}}
{{$productOrderCtrl.translations['antibody.pdp.commerceCard.promotion.viewpromo']}}
{{$productOrderCtrl.translations['antibody.pdp.commerceCard.promotion.promocode']}}: {{promo.promoCode}} {{promo.promoTitle}} {{promo.promoDescription}}. {{$productOrderCtrl.translations['antibody.pdp.commerceCard.promotion.learnmore']}}
产品信息
27027-1-AP
种属反应
宿主/亚型
分类
类型
抗原
偶联物
形式
浓度
规格
纯化类型
保存液
内含物
保存条件
运输条件
产品详细信息
Aliquoting is unnecessary for -20°C storage.
靶标信息
The trimeric complex of CDK7, cyclin H and MNAT1, functions as a Cdk-activating kinase (CAK). It is an essential component of the transcription factor TFIIH, that is involved in transcription initiation and DNA repair. This complex is thought to serve as a direct link between the regulation of transcription and the cell cycle. The bound complex is important in the normal double-strand break repair function of breast cancer, type 1 (BRCA1). CDK7 may be a target of germline cancer-inducing mutations.
仅用于科研。不用于诊断过程。未经明确授权不得转售。
生物信息学
蛋白别名: 39 KDa protein kinase; CAK; CDK; CDK-activating kinase; CDK-activating kinase 1; Cell division protein kinase 7; CR4 protein kinase; CRK4; CRK4 PK (CDC2-related-kinase-4 protein kinase); Cyclin-dependent kinase 7; cyclin-dependent kinase 7 (homolog of Xenopus MO15 cdk-activating kinase); cyclin-dependent kinase 7 (MO15 homolog, Xenopus laevis, cdk-activating kinase); EC 2.7.11.22; EC 2.7.11.23; homolog of Xenopus MO15 Cdk-activating kinase; kinase subunit of CAK; OTTHUMP00000222032; OTTHUMP00000222033; P39 Mo15; Protein-tyrosine kinase MPK-7; serine/threonine kinase stk1; serine/threonine protein kinase 1; serine/threonine protein kinase MO15; Serine/threonine-protein kinase 1; TFIIH basal transcription factor complex kinase subunit
基因别名: AI323415; AI528512; C230069N13; CAK; CAK1; CDK7; CDKN7; Crk4; HCAK; MO15; Mpk-7; p39MO15; STK1
UniProt ID: (Human) P50613, (Mouse) Q03147
Entrez Gene ID: (Human) 1022, (Mouse) 12572